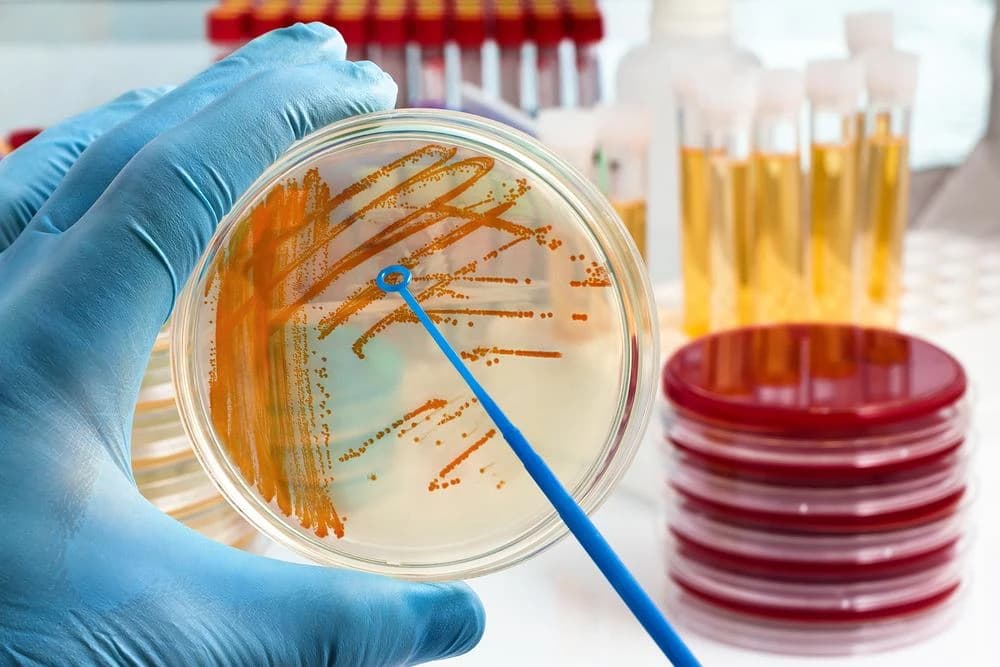
Liczne bakterie w moczu - usunięcie, diagnostyka, leczenie

Poznaj przyczyny, objawy i metody leczenia chorób zapalnych jelit, w tym choroby Leśniowskiego-Crohna i wrzodziejącego zapalenia jelita grubego. Skuteczne terapie farmakologiczne i dietetyczne.
Jestem założycielem i głównym autorem portalu o zdrowiu, który powstał z mojej pasji do medycyny i zdrowego stylu życia. Jako wykwalifikowany dietetyk z wieloletnim doświadczeniem, postanowiłem dzielić się wiedzą, która pomaga ludziom żyć pełniej i zdrowiej. Moja misja to dostarczanie rzetelnych, opartych na badaniach informacji o żywieniu, fitnessie i zdrowiu psychicznym. Wierzę, że każdy ma prawo do dostępu do wiedzy, która może znacząco poprawić jakość życia. Dążę do tego, by mój portal był miejscem, gdzie czytelnicy znajdą praktyczne porady, inspiracje oraz wsparcie w dążeniu do lepszego zdrowia.

Poznaj przyczyny, objawy i metody leczenia chorób zapalnych jelit, w tym choroby Leśniowskiego-Crohna i wrzodziejącego zapalenia jelita grubego. Skuteczne terapie farmakologiczne i dietetyczne.

Dowiedz się, czym są drobnoustroje i poznaj ich różnorodne rodzaje - od szkodliwych bakterii po pożyteczne grzyby. Odkryj charakterystykę tych mikroskopijnych organizmów i ich kluczową rolę w naszym życiu.

Poznaj nowoczesne metody diagnostyczne umożliwiające kompleksową analizę bakterii w jelitach. Dowiedz się, jak wykryć zaburzenia mikrobioty i skutecznie je leczyć.

Poznaj skuteczne metody leczenia aft w przewodzie pokarmowym i zwalcz te bolesne owrzodzenia. Odkryj przyczyny ich powstawania, w tym infekcje bakteryjne, i dowiedz się, jak wspomagać proces gojenia dzięki lekom, ziołom i zdrowej diecie.

Badanie z kropli krwi - poznaj jego zastosowania, opinie pacjentów oraz przeciwwskazania. Dowiedz się, jak przeprowadza się to nieinwazyjne badanie i jakie informacje można z niego uzyskać. Odkryj również, czym jest badanie kalprotektyny w kale.

Entero Acidolac - suplement diety z probiotyczną bakterią Lactobacillus acidophilus. Poznaj działanie, wskazania, skutki uboczne i dawkowanie tego preparatu wspomagającego równowagę mikroflory jelitowej.

Poznaj kluczowe różnice między autyzmem a ADHD, ich przyczyny i dostępne formy terapii. Artykuł objaśnia objawy obu zaburzeń oraz wyzwania codziennego życia z autyzmem i ADHD.

Bóle brzucha u dzieci - poznaj najczęstsze przyczyny, objawy, wskazówki dot. leczenia i profilaktyki, w tym u 7-latka. Dowiedz się kiedy skonsultować się z lekarzem.

Ocena skuteczności innowacyjnego suplementu diety Biolatte w saszetkach. Poznaj skład, badania oraz opinie na temat Biolatte original i Biolatte oy.
Bakterie liczne w moczu to objaw zakażenia dróg moczowych. Poznaj przyczyny, diagnostykę i skuteczne leczenie antybiotykami bakterii w nasieniu i cewce moczowej.